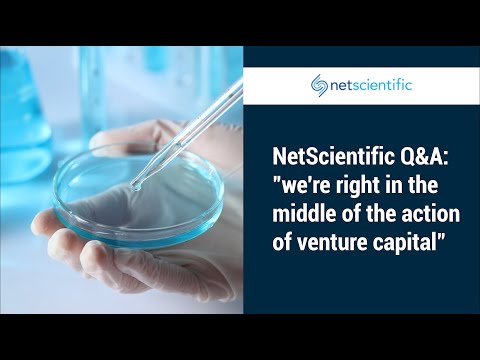
YouTube video thumbnail

By using voxmarkets.com, you agree to our Terms of Use and Privacy Policy.
All information provided on this website is for general information only and does not constitute investment advice.
Vox Markets Canada Inc does not make recommendations or offer investment, legal, or tax advice. You should always conduct your own due diligence and seek professional financial guidance before acting on any information presented here.
Prices, data, and company information are provided “as is” without warranty of accuracy or completeness.
Vox Markets Canada Inc accepts no responsibility for losses incurred from use of this website or any linked services.
© 2025 Vox Markets Canada Inc. All rights reserved.
Registered in Canada GST/HST 71773 4024 RT000
© 2026 Vox Markets. All rights reserved.